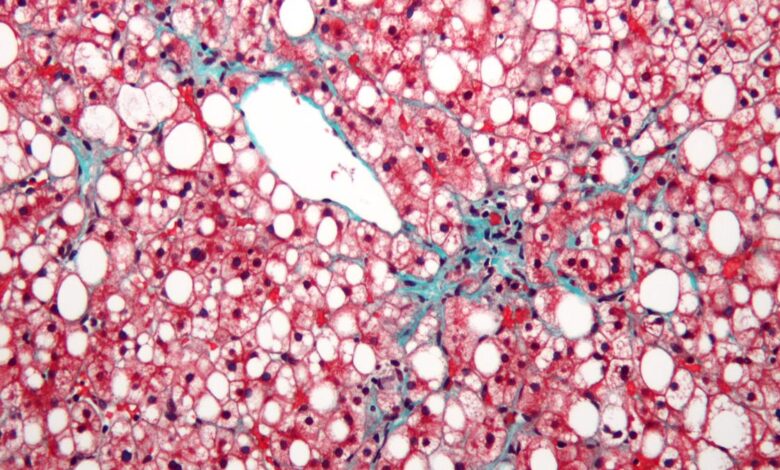

Naléhavá je třeba bojovat proti epidemii mastných játra v Indii
V Indii roste mastné onemocnění jater na alarmující míra. Nová terminologie vytvořená v roce 2023 pro mastné onemocnění jater je steatotické onemocnění jater. Během posledních pěti let různé studie ukázaly, že je ovlivněno 35–40% indické dospělé populace – a to je konzervativní odhad. Ještě více znepokojující je, že děti nejsou osvobozeny. Výzkum ukazuje, že přibližně 35% indických dětí má mastné onemocnění jater. Když kombinujeme čísla pro děti i dospělé, odhaduje se, že v současné době je ovlivněno 40–50 lidí v Indii. Toto je ohromující postava vzhledem k naší celkové populaci a zdůrazňuje naléhavost situace.
Mitdní játra nejsou jen samostatným stavem-často slouží jako varovný signál nebo spolupředseda o jiných hlavních onemocněních, jako je obezita, cukrovka, srdeční choroby, onemocnění ledvin, mrtvice a Dokonce i rakoviny. Jednotlivci s mastnými játry mají k těmto podmínkám také výrazně vyšší predispozici. Pokud by se nechala neadresovaná, mastná játra by mohla sněžit do hlavní národní zdravotní krize, což by vedlo ke komplikacím, jako je cirhóza jater, rakovina jater a vážná metabolická onemocnění. Nyní musíme jednat s povědomí veřejnosti, zásahy do životního stylu a včasným screeningem, abychom tuto rostoucí epidemii omezili.
Výskyt mastných jater
Mitdní játra doslova znamenají přebytečný tuk, který se ukládá v játrech. Jak se tento tuk staví, játra začne otok a postupem času ztrácí schopnost správně fungovat, což vede k různým zdravotním problémům. Hlavní příčinou je nesoulad mezi kaloriemi, které konzumujeme, a kaloriemi, které hoříme. Když jíme více mastných a kalorií hustých potravin-jako jsou zpracované potraviny, červené maso, smažené předměty a potraviny bohaté na olej-a nespálíme dostatek kalorií fyzickou aktivitou, přebytky kalorií se přeměňují na tuk a to se začne nahromadit v játrech.
Dnešní stravovací návyky často zahrnují velké množství zpracované a mastné potravinyv kombinaci s nízkou fyzickou aktivitou. Tento Zdravá kombinace má za následek stálé zvyšování skladování tuků v játrech.
Zpočátku mohou být usazeniny tuku v játrech malé a neškodné, ale pokud přetrvávají nezdravé návyky, tato depozity se postupně hromadí na nebezpečnou úroveň, což má za následek mastné onemocnění jater. Hlavními přispěvateli do této podmínky jsou nezdravá strava, sedavý životní styl a konzumace více kalorií než tělesné spálení. Aby se zabránilo a dokonce potenciálně zvrátilo mastné onemocnění jater, je nezbytná komplexní modifikace životního stylu, která se zaměřuje na stravu a fyzickou aktivitu.

Rizikové faktory
Je mastná játra vidět pouze u obézních jedinců?Ne. Ačkoli je obezita hlavním rizikovým faktorem, stav může také nastat u lidí s normální tělesnou hmotností, což je stav často označovaný jako libová mastná játra. To se může vyvinout z různých důvodů, včetně metabolických faktorů, jako je inzulínová rezistence, Diabetes 2. typuVysoký cholesterol, hypertenze a metabolický syndrom. Role může hrát také genetická predispozice, jako je rodinná anamnéza nebo určité genetické variace.
Návyky dietního a životního styluVýznamně také významně přispívají vysokou konzumací cukrů, rafinovaných uhlohydrátů, transfat, alkoholu a nedostatku fyzické aktivity. Kromě toho jsou příčiny hormonální a zdravotní stavy, jako je hypotyreóza, syndrom polycystických vaječníků (PCOS) a Cushingův syndrom. Některé léky, včetně kortikosteroidů, tamoxifenu, methotrexátu, amiodaronu a valproátu, mohou také vyvolat mastné játra. Nutriční problémy, jako je závažná podvýživa nebo rychlý úbytek hmotnosti, jakož i faktory související se střevem, jako je změněný střevní mikrobiom nebo tenké střevní bakteriální přerůstání (SIBO), mohou dále zvýšit riziko vzniku onemocnění.
Ve skutečnosti mohou být štíhlá mastná játra někdy zákeřnější, protože je méně podezřelá klinicky, ale stále nese riziko progrese zánětu, fibrózy, cirhózy a dokonce i rakoviny jater. Mitdní játra tedy nejsou jen onemocněním obezity – je to multifaktoriální metabolický a systémový stav, který vyžaduje pečlivé vyhodnocení základních příčin.

Nová terminologie
Obecně je termín SLD (steatotické onemocnění jater), což je deštníkový termín, který řeší jakýkoli důvod pro mastné játra. Termín NAFLD (nealkoholické mastné onemocnění jater) byl nedávno nahrazen, aby lépe odrážel spektrum onemocnění a základní příčiny. Pro lidi s obezitou nebo metabolickou chorobou se nazývá Masld (Metabolické dysfunkční steatotické onemocnění jater).
Prevence
Hned od začátku lze zabránit z mastné játra se správnou kontrolou stravy a změnami zdravého životního stylu.
Udržování zdraví jater Začíná jíst vyváženou stravu, která zahrnuje odpovídající proteiny, střední množství zdravých uhlohydrátů a minimální nezdravé tuky, a zároveň zahrnuje spoustu zeleniny, ovoce, celých zrn a ořechů. Pravidelná fyzická aktivita je stejně důležitá: zapojení do činností, jako je chůze, jogging, cyklistika nebo sporty po dobu nejméně 40 až 45 minut denně pět dní v týdnu, může významně změnit.
Pro ty, kteří mají diabetes, je zásadní udržovat hladinu cukru v krvi pod kontrolou prostřednictvím správné stravy, cvičení a lékařského vedení. Podobně, řízení vysokého cholesterolu se změnami životního stylu, léky, pokud jsou předepsány, a pravidelná lékařská sledování pomáhá chránit játra. Dosažení a udržování ideální tělesné hmotnosti je jedním z nejúčinnějších způsobů, jak zvrátit mastné játra, přičemž pro ty postižené je důrazně doporučeno snížení tělesné hmotnosti přinejmenším 10%.
Tím, že budete opatrní při výběru potravin, zůstanou aktivní a správa základních zdravotních stavů, mohou být mastné játra zcela zabráněny.
Přečtěte si také:Snížení tuku v játrech snižuje riziko nealkoholického mastného onemocnění jater: Studie UOH
Detekce
Detekce mastných jater vyžaduje úsilí z naší strany. Většina případů je objevena náhodou během rutinní kontroly zdraví, protože v raných stádiích mastná játra obvykle nevytváří žádné příznaky. Jakmile však postupuje do vysoce kvalitních mastných jater, fibrózy nebo cirhózy, mohou se příznaky začít objevovat-často, když již došlo k významnému poškození jater. To zdůrazňuje důležitost preventivních zdravotních kontrol.
Lidé, kteří jsou vystaveni vyššímu riziku, jako jsou ti, kteří jsou obéznímít vysoký cholesterol nebo je diabetik, by měl pravidelně sledovat zdraví jater, aby vyloučil mastné onemocnění jater. To lze provést pomocí jednoduchých a účinných metod detekce. Ultrazvuk břicha může pomoci při detekci a třídění mastných jater. Testy jaterních funkcí (LFT) jsou užitečné při identifikaci jakéhokoli poškození nebo abnormálního fungování způsobeného mastnými ložisky v játrech. Pokročilejší možnosti, jako je přechodná elastografie nebo neinvazivní testy na bázi ultrazvuku, nejen kvantifikují rozsah mastných jater, ale také detekují fibrózu, což z nich činí velmi cenné nástroje při rozhodování o vhodném průběhu léčby.
Neměli bychom čekat, až způsobí příznaky mastných játra. Pravidelný, proaktivní screening je naší odpovědností – umožňuje včasné detekci a včasné ošetření, aby se zabránilo komplikacím.
Přečtěte si také:Kerala zřídit kliniky mastných jater v okresních nemocnicích
Vhodné řízení
Jakmile je diagnostikována mastná játra, měla by léčba začít neprodleně, dokonce i ve stupni 1. stupně. Protože většina případů je identifikována ve stupni 1 nebo 2, zaměření v těchto fázích se zaměřuje především na změny životního stylu a dietních změn. Pravidelná fyzická aktivita a vyhýbání se dlouhodobým sedavým návykům hrají v řízení klíčovou roli. A Vyvážená strava S přívodem s vysokým obsahem bílkovin se důrazně doporučuje mírné uhlohydráty, omezené nezdravé tuky a spoustou zeleniny, ovoce a ořechů. Stejně důležité je udržovat diabetes, cholesterol a krevní tlak pod dobrou kontrolou, protože tyto podmínky často koexistují s mastnými játry. Dosažení a udržování ideální tělesné hmotnosti je nezbytné, přičemž vědecké důkazy ukazují, že snižování hmotnosti je nejúčinnějším způsobem zvrácení mastných játra. Pro kohokoli diagnostikovaného stavu se doporučuje minimálně 10% úbytek hmotnosti.

Jsou potřeba léky?
Na rozdíl od všeobecného přesvědčení není rozhodnutí zahájit léky na mastné játra určeno známkou uvedené na ultrazvukové zprávě. Místo toho záleží na několika klíčových faktorech, včetně přítomnosti fibrózy, abnormalit v testech jaterních funkcí, koexistujících podmínek, jako je diabetes nebo vysoký cholesterol, a potřeby řešit obezitu s léky. S dostupností novějších léků navržených speciálně pro mastné játra a širší metabolický syndrom zahrnující diabetes, cholesterol a obezitu může být léčba nyní přizpůsobena tak, aby vyhovovala zdravotnímu profilu každého jednotlivce.

Neignorujte
Na začátku se mohou zdát neškodný stav mastných játra, ale pokud je to ignorováno, to může postupovat do vážných a potenciálně život ohrožujících komplikací. Bez včasného zásahu mohou mastná játra postupovat od zánětu jater, známé jako hepatitida, na vývoj jizvy zvané fibróza, a nakonec k cirhóze, což způsobuje trvalé a nevratné poškození jater. Cirhóza je závažným stádiem onemocnění jater, při kterém orgán již nemůže efektivně provádět své životně důležité funkce. Když onemocnění dosáhne pokročilých fází, jedinou dostupnou léčbou může být transplantace jater, což je velmi složitý a hlavní postup.

Dobrá zpráva
Mastná játra v jeho raných stádiích jsou reverzibilní se správnými léčbami a změnami životního stylu. Proto jsou včasné detekce a řízení kritické.
Je důležité udržovat pravidelnou kontrolu zdraví játra místo čekání na příznaky. Včasné jednání se správnou léčbou podle stádia mastných játra může pomoci zabránit jeho progresi a snížit riziko dosažení nevratného poškození. Ochrana játra dnes je klíčem k zajištění delšího a zdravého života.
(Dr. P. Sendhilnathan je chirurgický gastroenterolog a režisér, GEM Hospital, Chennai. Režisérka@geminstitute.in)



